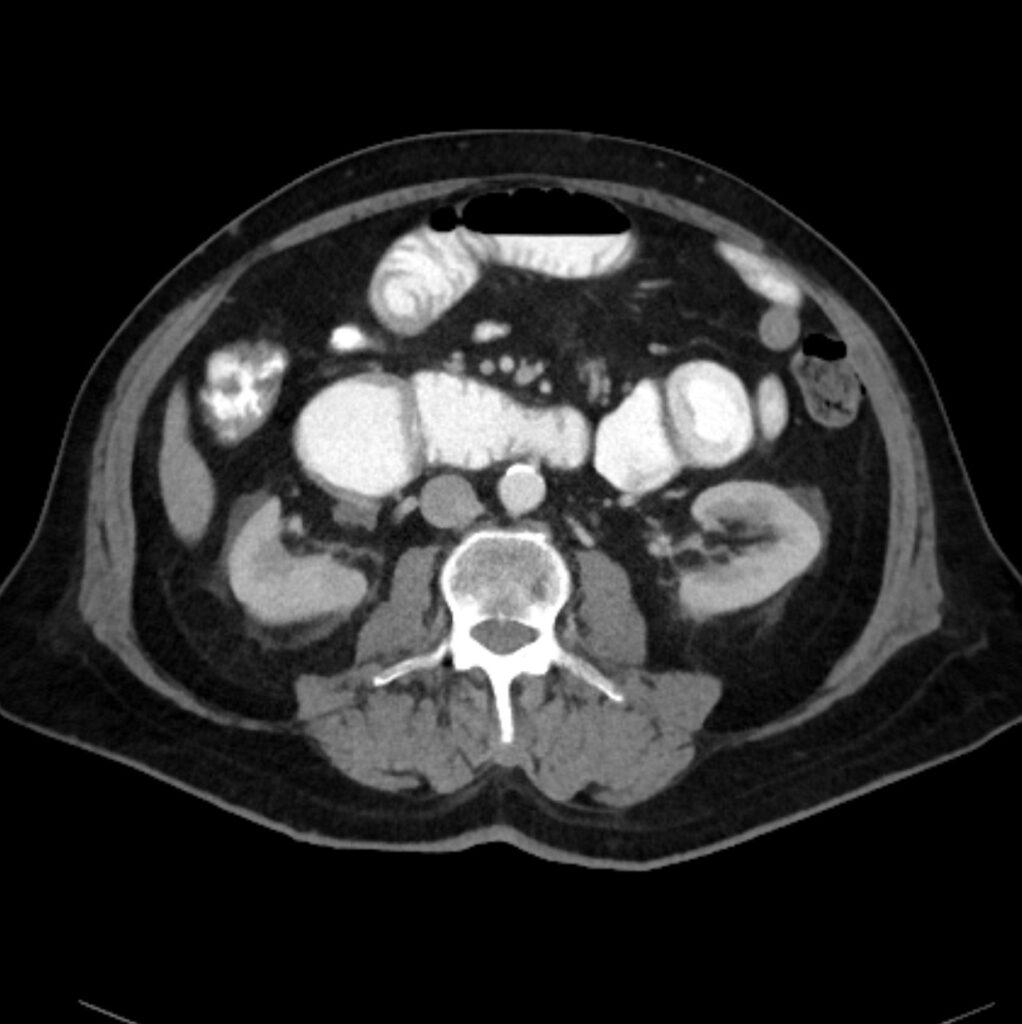

*72-year-old male with abdominal pain and vomiting.

What is the most likely diagnosis?
Answer
Answer: Small bowel mesentery internal hernia
Case Discussion:
CT images revealed the dilated loops, mesenteric edema, and beak-like point of obstruction
There are two types transmesenteric and intramesenteric small bowel internal hernia.
References:
1.Hong SS, Kim AY, Kim PN et-al. Current diagnostic role of CT in evaluating internal hernia. J Comput Assist Tomogr. 2005;29 (5): 604-9.
